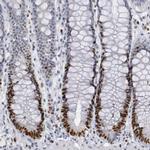
WDHD1 Antibody in Immunohistochemistry (IHC)

Search
Invitrogen
WDHD1 Polyclonal Antibody
{{$productOrderCtrl.translations['antibody.pdp.commerceCard.promotion.promotions']}}
{{$productOrderCtrl.translations['antibody.pdp.commerceCard.promotion.viewpromo']}}
{{$productOrderCtrl.translations['antibody.pdp.commerceCard.promotion.promocode']}}: {{promo.promoCode}} {{promo.promoTitle}} {{promo.promoDescription}}. {{$productOrderCtrl.translations['antibody.pdp.commerceCard.promotion.learnmore']}}
产品信息
PA5-51517
种属反应
宿主/亚型
分类
类型
偶联物
形式
浓度
规格
纯化类型
保存液
内含物
保存条件
运输条件
RRID
产品详细信息
Immunogen sequence: QTLNIVTWSP CGQYLAAGSI NGLIIVWNVE TKDCMERVKH EKGYAICGLA WHPTCGRISY TDAEGNLGLL ENVCDPSGKT SSSKVSSRVE KDYNDLFDGD DMSNAGDFLN DNAVE
Highest antigen sequence identity to the following orthologs: Mouse - 90%, Rat - 86%.
靶标信息
The protein encoded by this gene contains multiple N-terminal WD40 domains and a C-terminal high mobility group (HMG) box. WD40 domains are found in a variety of eukaryotic proteins and may function as adaptor/regulatory modules in signal transduction, pre-mRNA processing and cytoskeleton assembly. HMG boxes are found in many eukaryotic proteins involved in chromatin assembly, transcription and replication. Alternative splicing results in two transcript variants encoding different isoforms. [provided by RefSeq, Jul 2008].
仅用于科研。不用于诊断过程。未经明确授权不得转售。
篇参考文献 (0)
生物信息学
蛋白别名: Acidic nucleoplasmic DNA-binding protein 1; And-1; CTF4, chromosome transmission fidelity factor 4 homolog; unnamed protein product; WD repeat and HMG-box DNA-binding protein 1
基因别名: A630092E18; AND-1; AND1; CHTF4; CTF4; D630024B06Rik; WDHD1
UniProt ID: (Human) O75717, (Mouse) P59328
Entrez Gene ID: (Human) 11169, (Rat) 305827, (Mouse) 218973